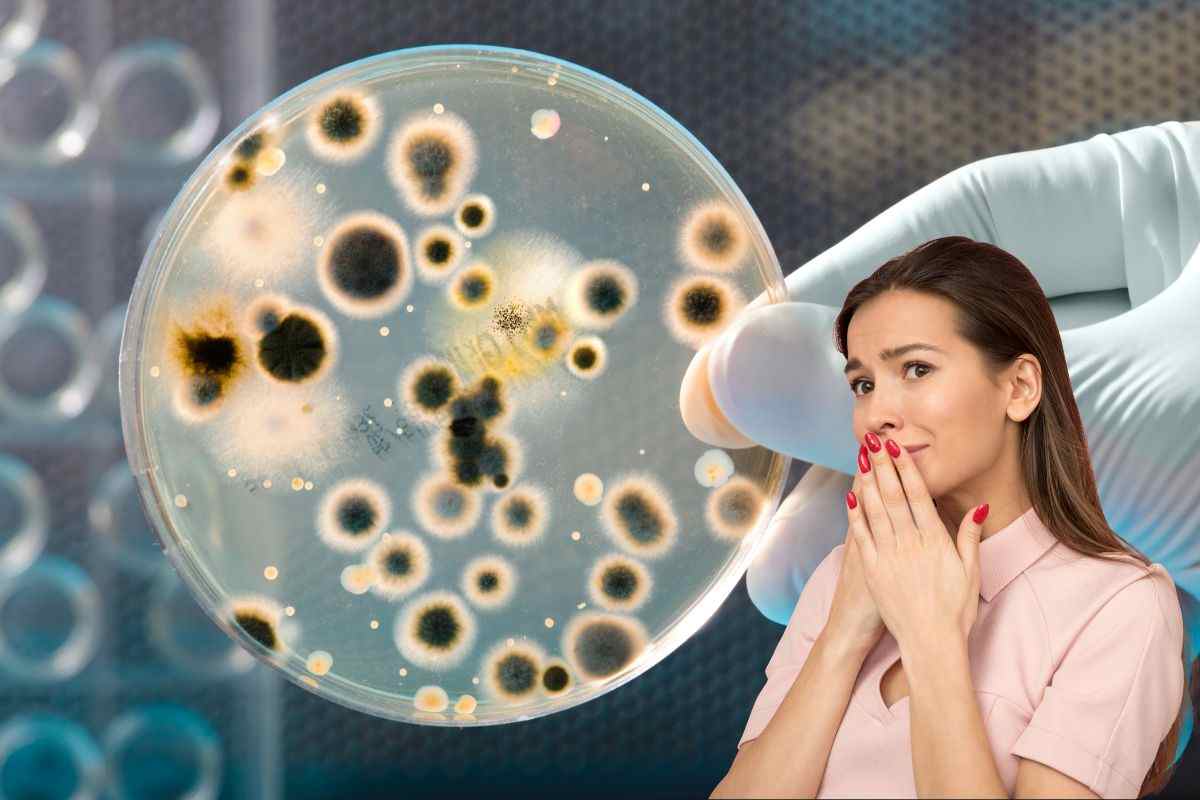

Altro che wc, quando scoprirai quali sono i posti più sporchi della casa resterai davvero senza parole: devi pulirli subito.
Non è certo il caso di ribadirlo nuovamente quanto sia indispensabile mantenere una casa sempre ben pulita ed igienizzata. Eliminare sporco, germi e batteri che si formano ogni giorno è una cosa a cui di certo non puoi rinunciare. Sicuramente non lo farai a cuor leggero, né tanto meno ti richiederà poco tempo, ma non potrai farne a meno.
Per svolgere tutto in modo perfetto e avere la certezza di non tralasciare nulla, per aiutarti potrai stilare una sorta di planning delle pulizie in cui andrai ad inserire tutto ciò che necessita di attenzioni giornaliere. Sulla base di questo, c’è una cosa che devi assolutamente sapere, ossia che in casa esistono dei luoghi che sono dei veri e proprio ricettacoli di germi e batteri e se stai pensando al wc sei completamente fuori strada, perché oggi non è di lui che ti parleremo.
Sono questi i posti più sporchi che ci sono in casa: quando li scopri correrai subito a pulirli
In casa sono davvero tantissimi gli ambienti che necessiteranno delle tue attenzioni. Alcuni dovrai pulirli ogni giorno e anche in modo piuttosto accurato, altri invece non avranno bisogno di queste attenzioni giornaliere. Ciò nonostante, devi sapere che alcuni di questi ambienti hanno al loro interno degli oggetti che per te rappresentano un vero pericolo. Sono talmente sporchi, che non appena li scoprirai correrai subito a pulirli.

Quando pensiamo agli oggetti più sporchi che abbiamo in casa, il wc è senza dubbio uno di quello che ci viene in mente per prima, eppure resterai stupita nel sapere che non è affatto così. Ebbene, in casa ci sono ben altri pericoli e alcuni li tocchi addirittura tutti i giorni.
I primi due oggetti in vetta alla classifica sono senza dubbio lo scopino del wc e la spugnetta dei piatti. Si trovano in ambienti diversi, eppure sono talmente sporchi che se solo potessi osservarli al microscopio resteresti sconvolta dalla quantità di germi e batteri che ci sono in superficie. Immediatamente dopo troviamo il telecomando. Si, hai letto bene è proprio lui ad essere al secondo posto tra gli oggetti più sporchi di casa. Lo tocchi praticamente sempre, un continuo passa mano che lo renderà un vero letamaio.
Passiamo poi agli interruttori e alle maniglie delle porte, anche queste le tocchi sempre e non è detto che ogni volta tu abbia le mani pulite. Una nota di merito anche alla pattumiera dell’umido, che raccoglie non solo sporco ma anche cattivo odori. Infine, non possiamo non citare tende e tappeti, che catturano fumo, sporco e polvere.